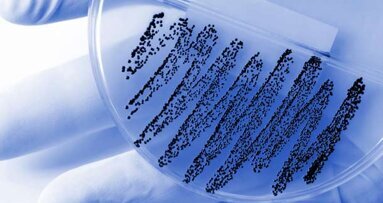
Die „Keim-Kette“: Hygiene-Falle beim Zahnarzt

Witten/Herdecke – Mit Expertise und Engagement hat er den Arbeitskreis über viele Jahre mitgestaltet, jetzt steht er an dessen Spitze: Prof. Dr. Joachim Jackowski, Inhaber des Lehrstuhls für Zahnärztliche Chirurgie und Poliklinische Ambulanz an der Universität Witten/Herdecke (UW/H), wurde auf dem diesjährigen Symposium der Arbeitsgemeinschaft für Oral- und Kieferchirurgie (AGOKi) und des Arbeitskreises für Oralpathologie und Oralmedizin (AKOPOM) unter dem Dach der Deutschen Gesellschaft für Zahn-, Mund- und Kieferheilkunde zum 1. Vorsitzenden des Arbeitskreises Oralpathologie und Oralmedizin gewählt.
Vor seiner Wahl war Prof. Jackowski im Beirat aktiv und ist seit vielen Jahren, unter anderem als Mandatsträger des AKOPOM, an der Erstellung zahlreicher zahnmedizinischer und medizinischer Leitlinien der Arbeitsgemeinschaft der Wissenschaftlichen Medizinischen Fachgesellschaften e. V. (AWMF) beteiligt.
Oralmedizin im Fokus: Früherkennung und Ausbildung stärken
Die moderne Zahn-, Mund- und Kieferheilkunde umfasst weit mehr als nur die hochspezialisierte Diagnostik und Behandlung von Zähnen und des Zahnhalteapparates. Sie verantwortet auch die Oralmedizin, die sich vor allem mit der Erkennung und Therapie von Veränderungen in der Mundhöhle bei Menschen mit anderen schweren Grunderkrankungen befasst. Dazu zählen sowohl primäre Erkrankungen der Mundschleimhaut als auch Beschwerden, die im Zusammenhang mit medizinischen Behandlungen auftreten – etwa infolge von Strahlen- oder Chemotherapie, Organtransplantationen oder Dialyse. Das Kauorgan und damit auch die Mundhöhle kann der erste Ort sein, an dem sich eine systemische Erkrankung bemerkbar macht. „Wir beobachten systemische Erkrankungen, die sich durch Veränderungen in der Mundhöhle äußern – zum Beispiel Schleimhautgeschwüre bei Morbus Crohn, Mundtrockenheit beim Sjögren-Syndrom oder Schleimhautentzündungen beim systemischen Lupus erythematodes“, erklärt Prof. Jackowski.
Außerdem ist es entscheidend, sogenannte orale potenziell maligne – also bösartige – Veränderungen frühzeitig erkennen und richtig einordnen zu können. Eine scheinbar profane Aphthe sollte beispielsweise nicht über Wochen als solche behandelt werden, da sie längst ein frühes Anzeichen für ein Mundhöhlenkarzinom sein kann. „Mit rund 10.000 Neuerkrankungen pro Jahr zählt dieser Krebs zu den zehn häufigsten bösartigen Tumorerkrankungen in Deutschland“, so Prof. Jackowski.
Deshalb fordert der Zahnmediziner noch mehr Aufmerksamkeit für die Oralmedizin und Oralpathologie in Forschung, Lehre und Praxis. An der UW/H sind diese Disziplinen längst fester Bestandteil des Studiums – und das, bevor es die neue zahnärztliche Approbationsordnung als Prüfungsfach „Querschnittsbereich Oralmedizin und systemische Aspekte“ vorschrieb. In seiner neuen Funktion als Vorsitzender sieht Prof. Jackowski die Chance, den Arbeitskreis Oralpathologie und Oralmedizin bereits unter Studierenden bekannter zu machen, damit sie vom interdisziplinären Austausch und den fachwissenschaftlichen Angeboten profitieren können.
Schlagwörter:
LEIPZIG – Dr. Jens Voss/Leipzig, Vorstandsmitglied der DGKZ, hat turnusgemäß zum 01.01.2012 das Amt des Präsidenten der 2003 ...
Hanau – Die Führung geht in vertraute Hände über: Kulzer hat mit Andre Sauer einen erfahrenen Branchenkenner und langjährigen Vertriebs- und ...
WITTEN / HERDECKE - Die Hygiene-Richtlinien des Robert-Koch-Instituts geben für die Reinigung der Patienten-Serviettenhalter keine eindeutigen ...
BONN – Der Freie Verband Deutscher Zahnärzte (FVDZ) fordert Korrekturen im TSVG, dessen erste Lesung am 13. Dezember 2018 im Parlament stattfand.
TIMMENDORFER STRAND – Der fünfte Dental Summer ließ weder vom Namen noch vom Anspruch her irgendwelche Wünsche offen. Die Sonne ...
Köln – Frauen haben die bessere Mundhygiene und nehmen zahnärztliche Vorsorgetermine regelmäßiger wahr als Männer. Dennoch sind sie häufiger von ...
Sydney – Kopfschmerzen und saubere Zähne, das scheint auf den ersten Blick wenig zusammenzuhängen. Doch eine aktuelle Studie der Universität Sydney ...
Berlin – Der Verband Deutscher Zahntechniker-Innungen (VDZI) weist die Anfang Februar öffentlich gewordenen Vorschläge des CDU-Wirtschaftsrates zur ...
BERLIN - Die Rolle der Parodontologie in Behandlung und Prävention am Beispiel der Wechselwirkungen von Parodontitis und Diabetes mellitus war ...
KÖLN - Zwischen 1991 und 2009 ist die Zahl der Extraktionen, die über die gesetzliche Krankenversicherung abgerechnet wurden, um fast 20 Prozent ...
Live-Webinar
Di. 23. Juni 2026
2:00 Uhr CET (Berlin)
Live-Webinar
Di. 23. Juni 2026
19:00 Uhr CET (Berlin)
Live-Webinar
Di. 23. Juni 2026
21:00 Uhr CET (Berlin)
Live-Webinar
Mi. 24. Juni 2026
14:00 Uhr CET (Berlin)
Live-Webinar
Mi. 24. Juni 2026
17:00 Uhr CET (Berlin)
Live-Webinar
Mi. 24. Juni 2026
18:30 Uhr CET (Berlin)
Dr. med. dent. Britta Hahn
Live-Webinar
Do. 25. Juni 2026
20:00 Uhr CET (Berlin)
Dr. Hatem Algraffee, Cat Edney



 Österreich / Österreich
Österreich / Österreich
 Bosnien und Herzegowina / Босна и Херцеговина
Bosnien und Herzegowina / Босна и Херцеговина
 Bulgarien / България
Bulgarien / България
 Kroatien / Hrvatska
Kroatien / Hrvatska
 Tschechien & Slowakei / Česká republika & Slovensko
Tschechien & Slowakei / Česká republika & Slovensko
 Frankreich / France
Frankreich / France
 Deutschland / Deutschland
Deutschland / Deutschland
 Griechenland / ΕΛΛΑΔΑ
Griechenland / ΕΛΛΑΔΑ
 Ungarn / Hungary
Ungarn / Hungary
 Italien / Italia
Italien / Italia
 Niederlande / Nederland
Niederlande / Nederland
 Nordic / Nordic
Nordic / Nordic
 Polen / Polska
Polen / Polska
 Portugal / Portugal
Portugal / Portugal
 Rumänien & Moldawien / România & Moldova
Rumänien & Moldawien / România & Moldova
 Slowenien / Slovenija
Slowenien / Slovenija
 Serbien & Montenegro / Србија и Црна Гора
Serbien & Montenegro / Србија и Црна Гора
 Spanien / España
Spanien / España
 Schweiz / Schweiz
Schweiz / Schweiz
 Türkei / Türkiye
Türkei / Türkiye
 Großbritannien und Irland / UK & Ireland
Großbritannien und Irland / UK & Ireland
 International / International
International / International
 Brasilien / Brasil
Brasilien / Brasil
 Kanada / Canada
Kanada / Canada
 Lateinamerika / Latinoamérica
Lateinamerika / Latinoamérica
 USA / USA
USA / USA
 China / 中国
China / 中国
 Indien / भारत गणराज्य
Indien / भारत गणराज्य
 Pakistan / Pākistān
Pakistan / Pākistān
 Vietnam / Việt Nam
Vietnam / Việt Nam
 ASEAN / ASEAN
ASEAN / ASEAN
 Israel / מְדִינַת יִשְׂרָאֵל
Israel / מְדִינַת יִשְׂרָאֵל
 Algerien, Marokko und Tunesien / الجزائر والمغرب وتونس
Algerien, Marokko und Tunesien / الجزائر والمغرب وتونس
 Naher Osten / Middle East
Naher Osten / Middle East

To post a reply please login or register